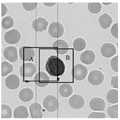

技术领域technical field
本发明涉及白细胞分类识别技术领域,特别是涉及一种白细胞分类模型用数据集的生成方法、系统及设备。The invention relates to the technical field of white blood cell classification and recognition, in particular to a method, system and equipment for generating a data set for a white blood cell classification model.
背景技术Background technique
正常的白细胞通常被分类为淋巴细胞、单核细胞、嗜中性粒细胞、 嗜酸性粒细胞及嗜碱性粒细胞。在正常的末梢血中,这些的白细胞各自以一定的比例存在。但是,当受试者存在疾病时,特定的白胞数增加或减少或者形态发生变化。所以,在临床检查的领域,通过进行白细胞的形态学分类计数与形态展示,对疾病的诊断极其有用。Normal white blood cells are generally classified into lymphocytes, monocytes, neutrophils, eosinophils and basophils. In normal peripheral blood, each of these white blood cells exists in a certain proportion. However, when the subject has a disease, the number of specific white blood cells increases or decreases or changes in shape. Therefore, in the field of clinical examination, it is extremely useful for the diagnosis of diseases by performing morphological classification, counting and morphological display of white blood cells.
现有白细胞形态学检测技术中,为了得到白细胞的种类数量及形态变化,一般需要对血细胞进行HE染色,然后再安排技术人员在显微镜下进行观察白细胞的形态和数量,然而,由于部分类型白细胞的细胞差异较小,这对血液学家的专业能力有一个很高的要求,整个分类计数的工作过程是枯燥且耗时的。In the existing white blood cell morphology detection technology, in order to obtain the types, quantities and morphological changes of white blood cells, it is generally necessary to perform HE staining on blood cells, and then arrange technicians to observe the shape and number of white blood cells under a microscope. However, due to the The cell difference is small, which has a high requirement on the professional ability of hematologists, and the whole working process of differential counting is boring and time-consuming.
由此,诞生了能够实现对白细胞自动分类的工业自动化细胞形态学系统,其主要是通过各种图像预处理操作将白细胞从血细胞染色图中提取出来并分割为细胞核区域与细胞质区域,并分别提取他们的形态与纹理等特征,从而制作数据集,最终利用机器学习的方法对提取的特征进行识别,从而实现白细胞的自动分类。然而不同的条件、光线分布和染色强度的变化都会对血涂片图像产生影响,传统的分割算法都会受到这类问题的影响,从而降低分割准确率导致特征提取不准确;在特征分类阶段,由于需要对特征进行降维处理从而损失部分特征,因此,传统的白细胞分割方法无法达到较高的分类精度。As a result, an industrial automated cell morphology system capable of automatically classifying white blood cells was born. It mainly extracts white blood cells from blood cell staining images through various image preprocessing operations and divides them into nuclear regions and cytoplasmic regions. Their shape and texture and other characteristics are used to create a data set, and finally the machine learning method is used to identify the extracted features, so as to realize the automatic classification of white blood cells. However, different conditions, changes in light distribution and staining intensity will affect the blood smear image, and traditional segmentation algorithms will be affected by such problems, which will reduce the accuracy of segmentation and lead to inaccurate feature extraction; in the feature classification stage, due to It is necessary to reduce the dimensionality of the features to lose some features. Therefore, the traditional white blood cell segmentation method cannot achieve high classification accuracy.
发明内容Contents of the invention
本发明的目的在于提出一种白细胞分类模型用数据集的生成方法、系统及设备,以解决传统白细胞分类计数过程中存在的准确率较低的问题。The object of the present invention is to propose a method, system and equipment for generating a data set for a white blood cell classification model to solve the problem of low accuracy in the traditional white blood cell classification and counting process.
本发明提出一种白细胞分类模型用数据集的生成方法,所述方法包括:The present invention proposes a method for generating a data set for a leukocyte classification model, the method comprising:
获取包含白细胞的苏木精-伊红染色图,采用第一预设尺寸的视野框按照第一预设步长遍历所述苏木精-伊红染色图,以根据遍历结果从所述苏木精-伊红染色图中提取多份子视野图像,所述第一预设步长小于所述视野框的边长;Acquiring a hematoxylin-eosin staining map containing leukocytes, traversing the hematoxylin-eosin staining map according to a first preset step size using a field of view frame of a first preset size, so as to extract from the hematoxylin-eosin staining map according to the traversal result Extracting multiple molecular field images from the sperm-eosin staining image, the first preset step size is smaller than the side length of the field of view frame;
基于预设染色分离规则对每份所述子视野图像进行染色分离,得到伊红染色图;Staining and separating each of the subfield images based on preset staining and separation rules to obtain an eosin staining map;
对每份所述伊红染色图进行预处理,以从所述伊红染色图中分离出染色元素和背景元素,并根据染色元素对应的预设像素范围获取预处理后的伊红染色图中满足所述预设像素范围的所有像素点坐标,以根据所述像素点坐标获取每一所述染色元素的轮廓坐标;Perform preprocessing on each of the eosin staining images to separate staining elements and background elements from the eosin staining images, and obtain preprocessed eosin staining images according to preset pixel ranges corresponding to the staining elements All pixel point coordinates satisfying the preset pixel range, so as to obtain the outline coordinates of each of the dyed elements according to the pixel point coordinates;
根据每一所述染色元素的轮廓坐标判断该染色元素是否为白细胞,若该染色元素为白细胞,则以该染色元素的轮廓中心点为分割中心从子视野图像中提取对应的固定大小的区域,得到多个第二预设尺寸的第一预训练图像;judging whether the dyed element is a white blood cell according to the contour coordinates of each dyed element, and if the dyed element is a white blood cell, extracting a corresponding fixed-size region from the sub-view image with the center point of the contour of the dyed element as the segmentation center, obtaining a plurality of first pre-training images of a second preset size;
根据第一预训练图像包含的白细胞类型将所有的所述第一预训练图像进行标注分类,并根据标注分类结果将所有的第一预训练图像制成数据集,以根据所述数据集对预设初始白细胞分类模型进行训练,得到最终白细胞分类模型。Label and classify all the first pre-training images according to the white blood cell types contained in the first pre-training images, and make all the first pre-training images into a data set according to the results of the label classification, so as to classify the pre-training images according to the data set The initial white blood cell classification model is set for training to obtain the final white blood cell classification model.
综上,根据上述的白细胞分类模型用数据集的生成方法,首先有规律地从伊红染色图中提取出多份子视野图像,同时第一预设步长小于用于提取的视野框的边长,以保证至少有一份子视野图像中存在完整的白细胞,而后利用预设染色分离规则快速将子视野图像进行快速分离,进而得到包含白细胞的伊红染色图,而后将每份伊红染色图进行预处理,进而分离出染色元素和背景元素,而后根据染色元素的预设像素范围精确识别出染色元素的轮廓坐标,进而判断出子视野图像中的染色元素是否确为白细胞,若判断到染色元素为白细胞,则按照之前获取到的染色元素的轮廓坐标对未处理前的子视野图像进行像素分割提取,如果该区域包含有其他的染色元素,将其像素值修改为背景均值,保证每个区域中仅有一个白细胞,进而得到规定尺寸的第一预训练图像,进而实现数据集的精确制作,从而得到最终细胞分类模型。通过将苏木精染色与伊红染色两种颜色利用染色向量进行拆解,从而去除白细胞区域的不相关背景信息,降低干扰提高分割精度。在伊红染色图像中,将只保留伊红与白细胞等化学反应产生的颜色信息,对伊红染色分离的图像再次进行二值化寻找白细胞轮廓,从而实现精准定位血细胞区域,进而生成高精度、高质量的数据集,保证后续训练得到的白细胞分类模型具有识别速度快、鲁棒性高、识别精度高的优点,进而能够快速且准确地实现对白细胞的分类和计数工作。To sum up, according to the above-mentioned generation method of the data set for the leukocyte classification model, firstly, multiple subfield images are regularly extracted from the eosin staining image, and at the same time, the first preset step size is smaller than the side length of the field frame used for extraction , to ensure that there are complete white blood cells in at least one sub-field image, and then quickly separate the sub-field images using the preset staining separation rules to obtain an eosin staining map containing white blood cells, and then pre-process each eosin staining map processing, and then separate the staining element and the background element, and then accurately identify the outline coordinates of the staining element according to the preset pixel range of the staining element, and then judge whether the staining element in the sub-field image is indeed a white blood cell, if it is judged that the staining element is For white blood cells, according to the contour coordinates of the dyed elements obtained before, the unprocessed sub-view image is pixel-divided and extracted. If the region contains other dyed elements, its pixel value is modified to the background mean value to ensure that each region There is only one white blood cell, and then the first pre-training image of the specified size is obtained, and then the precise production of the data set is realized, so as to obtain the final cell classification model. By dismantling the two colors of hematoxylin staining and eosin staining using the staining vector, the irrelevant background information of the white blood cell area is removed, and the interference is reduced to improve the segmentation accuracy. In the eosin stained image, only the color information produced by the chemical reaction between eosin and white blood cells will be retained, and the image separated by eosin staining will be binarized again to find the outline of white blood cells, so as to accurately locate the blood cell area, and then generate high-precision, High-quality data sets ensure that the white blood cell classification model obtained by subsequent training has the advantages of fast recognition speed, high robustness, and high recognition accuracy, and can quickly and accurately realize the classification and counting of white blood cells.
进一步地,所述对每份所述伊红染色图进行预处理,以从所述伊红染色图中分离出染色元素和背景元素,并根据染色元素对应的预设像素范围获取预处理后的伊红染色图中满足所述预设像素范围的所有像素点坐标,以根据所述像素点坐标获取每一所述染色元素的轮廓坐标的步骤包括:Further, preprocessing is performed on each of the eosin staining images to separate the staining elements and background elements from the eosin staining images, and obtain the preprocessed image according to the preset pixel range corresponding to the staining elements All pixel point coordinates in the eosin staining map satisfying the preset pixel range, so that the step of obtaining the outline coordinates of each of the dyed elements according to the pixel point coordinates includes:
对所述伊红染色图进行灰度化处理,以降低所述伊红染色图中染色元素的灰度值,得到与每一伊红染色图一一对应的灰度图;Carrying out grayscale processing on the eosin staining image to reduce the grayscale value of the dyeing elements in the eosin staining image to obtain a grayscale image corresponding to each eosin staining image;
根据预设图像阈值对所述灰度图进行二值化分割,以将所述灰度图中的染色元素和背景元素进行分离,得到二值化图像。The grayscale image is binarized and segmented according to a preset image threshold to separate dye elements and background elements in the grayscale image to obtain a binary image.
进一步地,所述根据每一所述染色元素的轮廓坐标判断该染色元素是否为白细胞的步骤包括:Further, the step of judging whether the dyed element is a white blood cell according to the outline coordinates of each dyed element includes:
获取多张已知白细胞区域的标准图像,并根据标准图像中已知白细胞区域的轮廓坐标计算出每一白细胞的面积,并从所有白细胞的面积中筛选出最小面积值,以根据所述最小面积值和预设分割安全系数的比值计算得到标准面积值;Obtain multiple standard images of known white blood cell areas, and calculate the area of each white blood cell according to the outline coordinates of the known white blood cell areas in the standard image, and filter out the minimum area value from the areas of all white blood cells to obtain the minimum area value according to the minimum area The standard area value is obtained by calculating the ratio of the value and the preset divisional safety factor;
根据所述染色元素的轮廓坐标计算每一所述染色元素的面积,并判断所述染色元素的面积是否大于或等于所述标准面积值;calculating the area of each of the dyed elements according to the outline coordinates of the dyed elements, and judging whether the area of the dyed elements is greater than or equal to the standard area value;
若所述染色元素的面积大于或等于所述标准面积值,则判断该染色元素为白细胞。If the area of the dyed element is greater than or equal to the standard area value, it is determined that the dyed element is a white blood cell.
进一步地,所述基于预设染色分离规则对每份所述子视野图像进行染色分离,得到伊红染色图的步骤包括:Further, the step of dyeing and separating each subfield image based on preset staining and separation rules to obtain an eosin staining map includes:
获取所述子视野图像中每个像素点的三通道像素值,以将每个像素点的三通道像素值转换为对应的光密度值,并根据像素点的光密度值构建一光密度矩阵;Acquiring the three-channel pixel value of each pixel in the sub-field image, converting the three-channel pixel value of each pixel into a corresponding optical density value, and constructing an optical density matrix according to the optical density value of the pixel;
将所述光密度矩阵进行SVD矩阵分解,以根据矩阵分解结果拟合出一标准平面,并获取每个像素点光密度值在所述标准平面上的投影分量,并根据所述投影分量将所述子视野图像进行染色分离,得到所述伊红染色图。Decomposing the optical density matrix into a SVD matrix to fit a standard plane according to the matrix decomposition results, and obtaining the projection component of the optical density value of each pixel point on the standard plane, and according to the projection component The subfield image is stained and separated to obtain the eosin staining map.
进一步地,所述若所述染色元素的面积大于或等于所述标准面积值,则判断该染色元素为白细胞的步骤之后还包括:Further, if the area of the dyed element is greater than or equal to the standard area value, the step of judging that the dyed element is a white blood cell further includes:
从所有的伊红染色图中筛选出染色元素为白细胞的目标图像,并根据遍历结果识别出任意相邻的两份目标图像,以根据相邻的两份目标图像中各自包含的白细胞的轮廓坐标判断相邻伊红染色图中的重叠区域是否存在重叠目标;Screen out the target images whose staining elements are leukocytes from all eosin staining images, and identify any two adjacent target images according to the traversal results, and use the outline coordinates of the leukocytes contained in each of the adjacent two target images Judging whether there are overlapping targets in the overlapping regions of adjacent eosin staining images;
所述根据相邻的两份目标图像中各自包含的白细胞的轮廓坐标判断相邻伊红染色图中的重叠区域是否存在重叠目标的步骤包括:The step of judging whether overlapping targets exist in overlapping regions in adjacent eosin staining images according to the outline coordinates of white blood cells contained in each of the two adjacent target images includes:
根据第一目标图像中的第一白细胞的轮廓坐标计算得到所述第一白细胞所在区域的面积,根据第二目标图像中的第二白细胞的轮廓坐标计算得到所述第二白细胞所在区域的面积,所述第一目标图像和所述第二目标图像为相邻目标图像;The area of the area where the first white blood cell is located is calculated according to the outline coordinates of the first white blood cell in the first target image, and the area of the area where the second white blood cell is located is calculated according to the outline coordinates of the second white blood cell in the second target image, The first target image and the second target image are adjacent target images;
根据第一白细胞所在区域的面积和第二白细胞所在区域的面积计算得到两白细胞所在区域的交集和并集,并根据两白细胞所在区域的交集和并集计算得到第一交并比;The intersection and union of the areas where the two white blood cells are located are calculated according to the area of the area where the first white blood cells are located and the area where the second white blood cells are located, and the first intersection and union ratio is calculated according to the intersection and union of the areas where the two white blood cells are located;
判断所述第一交并比是否大于第一预设交并比阈值;judging whether the first intersection and union ratio is greater than a first preset intersection and union ratio threshold;
若所述第一交并比大于所述第一预设交并比阈值,则判定所述重叠区域中存在重复目标,并将第一目标图像和第二目标图像中面积最大的目标白细胞对应的图像保留,得到第二预训练图像。If the first intersection and union ratio is greater than the first preset intersection and union ratio threshold, it is determined that there are repeated targets in the overlapping area, and the target leukocyte corresponding to the largest area in the first target image and the second target image is The image is retained to obtain the second pre-training image.
进一步地,所述对所述伊红染色图进行灰度化处理,以降低所述伊红染色图中染色元素的灰度值,得到与每一伊红染色图一一对应的灰度图的步骤包括:Further, the grayscale processing is performed on the eosin staining image to reduce the gray value of the dyeing elements in the eosin staining image, so as to obtain the grayscale image corresponding to each eosin staining image one-to-one. Steps include:
将所述伊红染色图的亮度增强至第一预设倍数,并获取亮度增强后的伊红染色图中的所有像素点的灰度值;Enhancing the brightness of the eosin-stained image to a first preset multiple, and obtaining gray values of all pixels in the enhanced-brightness eosin-stained image;
根据所有像素点的灰度值对亮度增强后的伊红染色图进行灰度变换;According to the gray value of all pixels, the brightness-enhanced eosin staining image is transformed into gray scale;
所述根据所有像素点的灰度值对亮度增强后的伊红染色图进行灰度变换的步骤包括:The step of performing grayscale transformation on the eosin stained image after brightness enhancement according to the grayscale values of all pixels includes:
根据以下公式对伊红染色图进行灰度变换:The grayscale transformation of the eosin-stained image was performed according to the following formula:
其中,i是指亮度增强后的伊红染色图中像素点的灰度值,G(x)是新的对应像素点的灰度值,[]表示取整数。Among them, i refers to the gray value of the pixel in the eosin staining image after brightness enhancement, G(x) is the gray value of the new corresponding pixel, and [] means to take an integer.
进一步地,所述获取所述子视野图像中每个像素点的三通道像素值,以将每个像素点的三通道像素值转换为对应的光密度值,并根据像素点的光密度值构建一光密度矩阵的步骤包括:Further, the acquisition of the three-channel pixel value of each pixel in the sub-view image converts the three-channel pixel value of each pixel into a corresponding optical density value, and constructs The steps of an optical density matrix include:
根据以下公式将每个像素点的三通道像素值转换为对应的光密度值:Convert the three-channel pixel value of each pixel to the corresponding optical density value according to the following formula:
其中,OD表示像素点的光密度值,value表示像素点的三通道像素值。Among them, OD represents the optical density value of the pixel point, and value represents the three-channel pixel value of the pixel point.
本发明还提出一种白细胞分类模型用数据集的生成系统,所述系统包括:The present invention also proposes a system for generating a data set for a leukocyte classification model, the system comprising:
子视野图像提取模块,用于获取包含白细胞的苏木精-伊红染色图,采用第一预设尺寸的视野框按照第一预设步长遍历所述苏木精-伊红染色图,以根据遍历结果从所述苏木精-伊红染色图中提取多份子视野图像,所述第一预设步长小于所述视野框的边长;The subfield of view image extraction module is configured to obtain a hematoxylin-eosin staining map containing white blood cells, and traverse the hematoxylin-eosin staining map according to a first preset step size using a field of view frame of a first preset size, to Extracting multiple molecular view images from the hematoxylin-eosin staining image according to the traversal result, the first preset step size is smaller than the side length of the view frame;
染色图像分离模块,用于基于预设染色分离规则对每份所述子视野图像进行染色分离,得到伊红染色图;A staining image separation module, configured to perform staining and separation on each of the subfield images based on preset staining separation rules to obtain an eosin staining image;
图像预处理模块,用于对每份所述伊红染色图进行预处理,以从所述伊红染色图中分离出染色元素和背景元素,并根据染色元素对应的预设像素范围获取预处理后的伊红染色图中满足所述预设像素范围的所有像素点坐标,以根据所述像素点坐标获取每一所述染色元素的轮廓坐标;An image preprocessing module, configured to preprocess each of the eosin staining images, so as to separate the staining elements and background elements from the eosin staining images, and obtain the preprocessing according to the preset pixel range corresponding to the staining elements Coordinates of all pixels in the subsequent eosin staining image satisfying the preset pixel range, so as to obtain the contour coordinates of each dyed element according to the coordinates of the pixel points;
染色元素分割模块,用于根据每一所述染色元素的轮廓坐标判断该染色元素是否为白细胞,若该染色元素为白细胞,则以该染色元素的轮廓中心点为分割中心从子视野图像中提取对应的固定大小的区域,得到多个第二预设尺寸的第一预训练图像;The staining element segmentation module is used to judge whether the staining element is a white blood cell according to the outline coordinates of each staining element, and if the staining element is a white blood cell, the center point of the outline of the staining element is used as the segmentation center to extract from the sub-view image A corresponding fixed-size region is obtained to obtain a plurality of first pre-training images of a second preset size;
数据集生成模块,用于根据第一预训练图像包含的白细胞类型将所有的所述第一预训练图像进行标注分类,并根据标注分类结果将所有的第一预训练图像制成数据集,以根据所述数据集对预设初始白细胞分类模型进行训练,得到最终白细胞分类模型。The data set generation module is used to label and classify all the first pre-training images according to the white blood cell types contained in the first pre-training images, and make all the first pre-training images into a data set according to the results of the label classification, so as to The preset initial white blood cell classification model is trained according to the data set to obtain a final white blood cell classification model.
本发明还提出一种可读存储介质,其上存储有计算机程序,该程序被处理器执行时实现上述的白细胞分类模型用数据集的生成方法。The present invention also proposes a readable storage medium on which a computer program is stored, and when the program is executed by a processor, the above-mentioned method for generating a data set for a leukocyte classification model is realized.
本发明还提出一种计算机设备,包括存储器、处理器以及存储在存储器上并可在处理器上运行的计算机程序,所述处理器执行所述程序时实现上述的白细胞分类模型用数据集的生成方法。The present invention also proposes a computer device, which includes a memory, a processor, and a computer program stored on the memory and operable on the processor. When the processor executes the program, the generation of the above-mentioned data set for the leukocyte classification model is realized. method.
本发明的附加方面和优点将在下面的描述中部分给出,部分将从下面的描述中变得明显,或通过本发明的实施例了解到。Additional aspects and advantages of the invention will be set forth in part in the description which follows, and in part will be apparent from the description which follows, or may be learned by practice of the invention.
附图说明Description of drawings
图1为本发明第一实施例白细胞分类模型用数据集的生成方法的流程图;1 is a flowchart of a method for generating a data set for a leukocyte classification model according to the first embodiment of the present invention;
图2为本发明第一实施例中的苏木精-伊红染色图的遍历提取示意图;Fig. 2 is a schematic diagram of the traversal extraction of the hematoxylin-eosin staining image in the first embodiment of the present invention;
图3为本发明第一实施例中的子视野提取效果图;FIG. 3 is an effect diagram of sub-view extraction in the first embodiment of the present invention;
图4为本发明第一实施例中的预设初始细胞分类模型的结构示意图;4 is a schematic structural diagram of a preset initial cell classification model in the first embodiment of the present invention;
图5为本发明第二实施例白细胞分类模型用数据集的生成方法的流程图;5 is a flowchart of a method for generating a data set for a leukocyte classification model according to the second embodiment of the present invention;
图6本发明第二实施例中的白细胞分割过程的效果示意图;6 is a schematic diagram of the effect of the white blood cell segmentation process in the second embodiment of the present invention;
图7为本发明第二实施例中步骤S106的细化图;FIG. 7 is a detailed diagram of step S106 in the second embodiment of the present invention;
图8为本发明第三实施例白细胞分类模型用数据集的生成系统的结构示意图。8 is a schematic structural diagram of a system for generating a data set for a leukocyte classification model according to a third embodiment of the present invention.
如下具体实施方式将结合上述附图进一步说明本发明。The following specific embodiments will further illustrate the present invention in conjunction with the above-mentioned drawings.
具体实施方式Detailed ways
为了便于理解本发明,下面将参照相关附图对本发明进行更全面的描述。附图中给出了本发明的若干实施例。但是,本发明可以以许多不同的形式来实现,并不限于本文所描述的实施例。相反地,提供这些实施例的目的是使对本发明的公开内容更加透彻全面。In order to facilitate the understanding of the present invention, the present invention will be described more fully below with reference to the associated drawings. Several embodiments of the invention are shown in the drawings. However, the present invention can be embodied in many different forms and is not limited to the embodiments described herein. Rather, these embodiments are provided so that the disclosure of the present invention will be thorough and complete.
除非另有定义,本文所使用的所有的技术和科学术语与属于本发明的技术领域的技术人员通常理解的含义相同。本文中在本发明的说明书中所使用的术语只是为了描述具体的实施例的目的,不是旨在于限制本发明。本文所使用的术语“及/或”包括一个或多个相关的所列项目的任意的和所有的组合。Unless otherwise defined, all technical and scientific terms used herein have the same meaning as commonly understood by one of ordinary skill in the technical field of the invention. The terms used herein in the description of the present invention are for the purpose of describing specific embodiments only, and are not intended to limit the present invention. As used herein, the term "and/or" includes any and all combinations of one or more of the associated listed items.
请参阅图1,所示为本发明第一实施例中的白细胞分类模型用数据集的生成方法的流程图,该方法包括步骤S01至步骤S05,其中:Please refer to FIG. 1, which shows a flowchart of a method for generating a data set for a leukocyte classification model in the first embodiment of the present invention, the method includes steps S01 to S05, wherein:
步骤S01:获取包含白细胞的苏木精-伊红染色图,采用第一预设尺寸的视野框按照第一预设步长遍历所述苏木精-伊红染色图,以根据遍历结果从所述苏木精-伊红染色图中提取多份子视野图像,所述第一预设步长小于所述视野框的边长;Step S01: Obtain a hematoxylin-eosin staining map containing white blood cells, traverse the hematoxylin-eosin staining map according to a first preset step size using a field of view frame of a first preset size, and obtain from all Extracting multiple molecular field images from the hematoxylin-eosin staining image, the first preset step size is smaller than the side length of the field of view frame;
需要说明的是,在本步骤中,首先利用苏木精和伊红将含有白细胞的血涂片进行染色,进而获取光学显微镜扫描仪扫描染色后的血涂片的图像,该图像即为苏木精-伊红染色图,由于苏木精-伊红染色图尺寸较大,为了降低后续的计算复杂度,首先需要将苏木精-伊红染色图分割成多份子视野图像,请参阅图2,所示为苏木精-伊红染色图的遍历提取示意图,在对苏木精-伊红染色图进行分割成多份子视野图像的过程中,为了防止出现一个完整的白细胞被分割成两部分的情况,第一预设步长需要小于视野框的两个边长,以确保相邻的子视野图像中存在重叠区域,该重叠区域指的是,前后、左右、对角相邻的子视野图像均存在重叠区域,同时重叠区域的宽度需要大于一个白细胞的直径,即视野框的边长分别与第一预设步长的差值均需大于一个白细胞的直径,以确保相邻的两份子视野图像中至少有一个完整的白细胞。It should be noted that in this step, the blood smear containing leukocytes is first stained with hematoxylin and eosin, and then the image of the stained blood smear scanned by an optical microscope scanner is obtained. Hematoxylin-eosin staining image, due to the large size of the hematoxylin-eosin staining image, in order to reduce the subsequent calculation complexity, it is first necessary to divide the hematoxylin-eosin staining image into multiple molecular field images, please refer to Figure 2 , shows the schematic diagram of the traversal extraction of the hematoxylin-eosin staining image. In the process of segmenting the hematoxylin-eosin staining image into multiple molecular field images, in order to prevent a complete white blood cell from being divided into two parts In the case of , the first preset step length needs to be smaller than the two side lengths of the field of view frame to ensure that there is an overlapping area in the adjacent sub-view images. There are overlapping areas in the images, and the width of the overlapping area needs to be greater than the diameter of a white blood cell, that is, the difference between the side length of the field of view frame and the first preset step length must be greater than the diameter of a white blood cell, so as to ensure that two adjacent molecules At least one intact leukocyte in the field image.
示例而非限定,针对像素点大小为33592×32520的苏木精-伊红染色图,以像素点大小为2048×2048的正方形窗口在图像上滑动,以像素点大小为1792的步长来固定提取我们子视野,对于数值不够2048的边界图像区域,直接获取所有的图像信息进行保存。通过这种方式,后一个视野跟前一个视野保持一个像素值为255的重叠区域,请参阅图3,所示为子视野提取效果图,图中竖直虚线为右边子视野图的轮廓线、而竖直实线为左边子视野图的轮廓线,通过上述特定的有规律的方法来提取子视野图像,进而使得B图像中得到包含完整的白细胞,而A图像中得到包含部分区域的白细胞,即实现至少有一个子视野图像含有完整的白细胞,从而提高后续制作数据集的精确度,从而提高分类模型的识别精确度。For example and not limitation, for a hematoxylin-eosin staining map with a pixel size of 33592×32520, a square window with a pixel size of 2048×2048 is used to slide on the image, and the pixel size is fixed at a step size of 1792 Extract our subfield of view, and directly obtain all the image information for the boundary image area whose value is not enough to 2048 and save it. In this way, the latter field of view and the previous field of view maintain an overlapping area with a pixel value of 255. Please refer to Figure 3, which shows the rendering of the subfield of view extraction. The vertical dotted line in the figure is the outline of the right subfield of view, while The vertical solid line is the contour line of the left sub-view image, and the sub-view image is extracted through the above-mentioned specific and regular method, so that the B image contains complete white blood cells, and the A image contains white blood cells in a partial area, that is Realize that at least one subfield of view image contains complete white blood cells, thereby improving the accuracy of subsequent production data sets, thereby improving the recognition accuracy of the classification model.
还需补充说明的是,为了提高后续细胞分类计数的效率,在得到多份子视野图像后,会对这些子视野图像进行二值化处理,以根据得到的二值化图像初步将明显不含有白细胞特征的子视野图像舍弃,具体为遍历二值化图像中各个轮廓的面积值,并判断是否存在与白细胞轮廓面积相近的,如果存在,则说明该子视野图像可能含有白细胞特征,若不存在,则说明子视野图像明显不含有白细胞特征,进而将不含有白细胞特征的子视野图像舍弃。It should be added that, in order to improve the efficiency of subsequent cell classification and counting, after obtaining multiple sub-field images, these sub-field images will be binarized, so as to preliminarily identify cells that do not contain white blood cells based on the obtained binarized images. The sub-view image of the feature is discarded, specifically traversing the area value of each contour in the binarized image, and judging whether there is an area similar to the white blood cell contour area. If it exists, it means that the sub-view image may contain white blood cell features. If not, It indicates that the subfield of view images obviously do not contain white blood cell features, and then the subfield of view images that do not contain white blood cell features are discarded.
步骤S02:基于预设染色分离规则对每份所述子视野图像进行染色分离,得到伊红染色图;Step S02: Perform staining and separation on each of the sub-field images based on preset staining and separation rules to obtain an eosin staining map;
可以理解的,按照预设染色分离规则将苏木精-伊红染色图进行染色分离,进而得到苏木精染色图和伊红染色图。It can be understood that the hematoxylin-eosin staining map is stained and separated according to preset staining separation rules, and then the hematoxylin staining map and the eosin staining map are obtained.
步骤S03:对每份所述伊红染色图进行预处理,以从所述伊红染色图中分离出染色元素和背景元素,并根据染色元素对应的预设像素范围获取预处理后的伊红染色图中满足所述预设像素范围的所有像素点坐标,以根据所述像素点坐标获取每一所述染色元素的轮廓坐标;Step S03: Perform preprocessing on each of the eosin staining images to separate the staining elements and background elements from the eosin staining images, and obtain the preprocessed eosin according to the preset pixel range corresponding to the staining elements Coordinates of all pixels in the dyeing map satisfying the preset pixel range, so as to obtain the outline coordinates of each dyed element according to the coordinates of the pixel points;
可以理解的是,预处理过程依次包括灰度化处理、二值化处理以及形态学操作,以消除图像噪音点等背景干扰,进而实现对伊红染色图中染色元素和背景元素的精确分离。It can be understood that the preprocessing process includes grayscale processing, binarization processing, and morphological operations in order to eliminate background interference such as image noise points, and then achieve accurate separation of stained elements and background elements in the eosin stained image.
需要指出的是,染色元素对应的预设像素范围一般是基于伊红对白细胞进行染色后,通过筛选采集到的白细胞所在区域中各个像素点的像素值中最小的像素数值和最大的像素数值而制定的,为了提高染色元素提取的准确性,一般还会设定一提取容错系数,即预设像素范围中的下限值为最小像素值与该提取容错系数的比值,预设像素范围的上限值为最大像素值与该提取容错系数的乘积。而后按照该预设像素范围对染色元素所在区域进行锁定分割,进而实现对染色元素的准确分割。It should be pointed out that the preset pixel range corresponding to the staining element is generally based on eosin staining of white blood cells, and is obtained by screening the smallest pixel value and the largest pixel value among the pixel values of each pixel in the area where the white blood cells are located. In order to improve the accuracy of dyeing element extraction, an extraction error tolerance coefficient is generally set, that is, the lower limit of the preset pixel range is the ratio of the minimum pixel value to the extraction error tolerance coefficient, and the upper limit of the preset pixel range is The limit is the product of the maximum pixel value and the extraction tolerance factor. Then, according to the preset pixel range, the region where the dyed element is located is locked and segmented, thereby realizing accurate segmentation of the dyed element.
步骤S04:根据每一所述染色元素的轮廓坐标判断该染色元素是否为白细胞,若该染色元素为白细胞,则以该染色元素的轮廓中心点为分割中心从子视野图像中提取对应的固定大小的区域,得到多个第二预设尺寸的第一预训练图像;Step S04: Determine whether the dyed element is a white blood cell according to the contour coordinates of each dyed element, and if the dyed element is a white blood cell, extract the corresponding fixed size from the sub-view image with the center point of the contour of the dyed element as the segmentation center In the region, a plurality of first pre-training images of the second preset size are obtained;
需要指出的是,在提取固定大小的区域时,需要根据为白细胞的染色元素的轮廓坐标确定该染色元素的轮廓中心点,进而以该轮廓中心点为分割中心进行分割,此外,如果该区域还包含有其他的染色元素,则将其它染色元素的像素值修改为背景均值,具体为根据白细胞的染色元素的轮廓坐标确定背景元素,背景元素内可能会包括其他染色元素,进而再遍历所有背景元素的像素值,以根据背景元素的像素值计算出背景均值,进而将背景元素的像素均修改为背景均值,以实现将其他染色元素进行隐藏,以保证每个区域中仅有一个白细胞,避免后续步骤出现干扰导致重复计数,从而得到多个第二预设尺寸的第一预训练图像;It should be pointed out that when extracting a region of fixed size, it is necessary to determine the contour center point of the stained element according to the contour coordinates of the stained element of white blood cells, and then use the contour center point as the segmentation center for segmentation. In addition, if the region is still If other staining elements are included, modify the pixel values of other staining elements to the background mean value. Specifically, the background element is determined according to the outline coordinates of the staining elements of white blood cells. The background element may include other staining elements, and then traverse all the background elements The pixel value of the background element is used to calculate the background mean value according to the pixel value of the background element, and then all the pixels of the background element are modified to the background mean value, so as to hide other dyed elements, so as to ensure that there is only one white blood cell in each area, and avoid subsequent Interference in the step causes repeated counting, thereby obtaining a plurality of first pre-training images of the second preset size;
可以理解的是,由于伊红染色图中存在的染色元素有可能是单个白细胞,也有可能是血小板等,需要对每一伊红染色图中各自存在的染色元素进行识别,以确认该染色元素是否为白细胞,若不是白细胞,则将没有白细胞的染色元素所在的伊红染色图舍弃,若该染色元素为白细胞,则按照之前获取到所有的该白细胞的轮廓坐标对原始的子视野图像进行像素分割提取,需要特别说明的是,在本步骤中的分割对象是未处理前的苏木精-伊红染色图或子视野图像,同时确保所有的预训练图像的格式一致,进而确保后续的训练过程,例如:所有预训练图像均只包括一个白细胞区域和非白细胞区域(背景区域)两部分、所有的预训练图像的尺寸一致。It is understandable that since the staining elements in the eosin staining pattern may be single white blood cells or platelets, it is necessary to identify the respective staining elements in each eosin staining pattern to confirm whether the staining element is It is a white blood cell. If it is not a white blood cell, the eosin staining map where the staining element without white blood cells is located is discarded. If the staining element is a white blood cell, the original sub-view image is pixel-divided according to the outline coordinates of all the white blood cells obtained before. Extraction. It should be noted that the segmentation object in this step is the unprocessed hematoxylin-eosin staining image or subfield image, and at the same time ensure that the format of all pre-training images is consistent, thereby ensuring that the subsequent training process , for example: all pre-training images only include a white blood cell area and a non-white blood cell area (background area), and all pre-training images have the same size.
具体的,设置第二预设尺寸的目的是为了固定以及缩小需要进行训练的图像,在本实施例中,第二预设尺寸设置为512*512。Specifically, the purpose of setting the second preset size is to fix and reduce the images that need to be trained. In this embodiment, the second preset size is set to 512*512.
步骤S05:根据第一预训练图像包含的白细胞类型将所有的所述第一预训练图像进行标注分类,并根据标注分类结果将所有的第一预训练图像制成数据集,以根据所述数据集对预设初始白细胞分类模型进行训练,得到最终白细胞分类模型。Step S05: Label and classify all the first pre-training images according to the leukocyte types contained in the first pre-training images, and make all the first pre-training images into a data set according to the results of the label classification, so that according to the data Set to train the preset initial leukocyte classification model to obtain the final leukocyte classification model.
需要说明的是,标注分类的结果为淋巴细胞、单核细胞、嗜中性粒细胞、 嗜酸性粒细胞及嗜碱性粒细胞5种白细胞以及涂抹细胞、巨核细胞、聚集血小板3种非白细胞,在得到数据集后,将数据集按照8:2分为训练集及测试集并通过数据增强的方式从而实现训练集各个类别的样本均衡,而后再对训练集进行预处理操作,具体为:对图像随机裁剪到原始图像面积的8%到100%,宽高比在3/4和4/3之间随机选择。然后再通过线性插值的方式将图像像素点变为256*256,对其每个通道的数据进行标准化,即对R、G、B每个通道的值分别减去对应通道整个数据集的均值然后除以对应通道整个数据集的方差,最后再将该训练集处理成深度学习模型所需的图片格式。It should be noted that the results of labeling and classification are 5 types of white blood cells including lymphocytes, monocytes, neutrophils, eosinophils, and basophils, and 3 types of non-leukocytes including smear cells, megakaryocytes, and aggregated platelets. After obtaining the data set, the data set is divided into training set and test set according to 8:2, and the sample balance of each category of the training set is realized by means of data enhancement, and then the training set is preprocessed, specifically: The image is randomly cropped to 8% to 100% of the original image area, and the aspect ratio is randomly selected between 3/4 and 4/3. Then, the image pixels are changed to 256*256 by linear interpolation, and the data of each channel is standardized, that is, the value of each channel of R, G, and B is subtracted from the mean value of the entire data set of the corresponding channel and then Divide by the variance of the entire data set of the corresponding channel, and finally process the training set into the image format required by the deep learning model.
进一步地,请参阅图4,所示为预设初始细胞分类模型的结构示意图,其构建过程具体为:该预设初始细胞分类模型包括10个卷积层(C1-C10),2个最大池化层(P4与P2),一个自适应平均池化层(AP)以及三个全连接层。在第一个卷积层(C1)采用7*7的卷积核,在其余的卷积层,为了降低模型的复杂度我们采用了3*3与1*1的卷积核,进而能够提高了模型的训练与测试速度,在这个架构上,添加2个‘短连接’操作(残差函数),该结构有利于模型在训练过程的优化,将第一个卷积层的特征与最后一个卷积层的特征融合,能够给全连接层提供更详细的局部特征。除此之外,利用特征融合操作将浅层的特征融合到下一层进行传播,这能够细化图像的特征,基于此,在特征融合层融合了第一层与两个‘短连接’操作后的特征,在每个卷积层之后,采用批量归一化操作,整个网络均采用ReLU 作为模型的激活函数,它能够有效克服梯度消失,增加训练速度。在全连接层之前, 应用一个自适应的平均池化层,它能够有效的降低进入全连接层的特征数量,进而降低模型复杂度,全连接层的第一、二层的dropout(随机丢弃)为0.5,第三层为0,使用一个3层结构的全连接层,特征数量分别是128、64、8,各个层之间的具体参数如下表1所示:Further, please refer to Figure 4, which shows a schematic structural diagram of the preset initial cell classification model, and its construction process is as follows: the preset initial cell classification model includes 10 convolutional layers (C1-C10), and 2 maximum pooling layers layer (P4 and P2), an adaptive average pooling layer (AP) and three fully connected layers. In the first convolution layer (C1), a 7*7 convolution kernel is used. In the remaining convolution layers, in order to reduce the complexity of the model, we use a 3*3 and 1*1 convolution kernel, which can improve Improve the training and testing speed of the model. On this architecture, add 2 'short connection' operations (residual function), this structure is conducive to the optimization of the model during the training process, combining the features of the first convolution layer with the last The feature fusion of the convolutional layer can provide more detailed local features to the fully connected layer. In addition, the feature fusion operation is used to fuse the shallow features to the next layer for propagation, which can refine the features of the image. Based on this, the first layer and two 'short connection' operations are integrated in the feature fusion layer The final features, after each convolutional layer, adopt batch normalization operation, and the entire network uses ReLU as the activation function of the model, which can effectively overcome the gradient disappearance and increase the training speed. Before the fully connected layer, an adaptive average pooling layer is applied, which can effectively reduce the number of features entering the fully connected layer, thereby reducing the complexity of the model. The dropout of the first and second layers of the fully connected layer (randomly discarded) is 0.5, the third layer is 0, and a fully connected layer with a 3-layer structure is used. The number of features is 128, 64, and 8 respectively. The specific parameters between each layer are shown in Table 1 below:
表1Table 1
完成对预设初始细胞分类模型的构建后,进而开始模型的训练过程,采用小批量随机梯度下降法来迭代优化模型的参数,初试学习率为0.001,训练100代,每10代学习率变为原来数值的10%,损失函数模型采用交叉熵损失函数,训练结束后,将100代中,测试集效果最好的模型作为深度学习算法最优模型,即得到最终细胞分类模型,如果准确率较低,将重复上述优化模型参数,直至符合要求。After the construction of the preset initial cell classification model is completed, the training process of the model is started, and the parameters of the model are iteratively optimized by using the small batch stochastic gradient descent method. The learning rate of the initial test is 0.001, and the training is 100 generations. 10% of the original value, the loss function model adopts the cross entropy loss function. After the training, the model with the best test set effect in the 100 generations is used as the optimal model of the deep learning algorithm, that is, the final cell classification model is obtained. If the accuracy rate is higher than Low, the above optimization model parameters will be repeated until the requirements are met.
可以理解的是,在得到最终细胞分类模型后,进而输入需要进行识别的待识别图像,以得到待识别图像中具体的白细胞种类,对于非白细胞不进行统计,并按照分类后的结果进行计数,进而得到各类白细胞的具体数量或比例。It can be understood that after the final cell classification model is obtained, the image to be identified that needs to be identified is then input to obtain the specific type of white blood cells in the image to be identified, and non-white blood cells are not counted, and counted according to the classified results. Then the specific number or ratio of various types of white blood cells can be obtained.
综上,根据上述的白细胞分类模型用数据集的生成方法,首先有规律地从伊红染色图中提取出多份子视野图像,同时第一预设步长小于用于提取的视野框的边长,以保证至少有一份子视野图像中存在完整的白细胞,而后利用预设染色分离规则快速将子视野图像进行快速分离,进而得到包含白细胞的伊红染色图,而后将每份伊红染色图进行预处理,进而分离出染色元素和背景元素,而后根据染色元素的预设像素范围精确识别出染色元素的轮廓坐标,进而判断出子视野图像中的染色元素是否确为白细胞,若判断到染色元素为白细胞,则按照之前获取到的染色元素的轮廓坐标对未处理前的子视野图像进行像素分割提取,如果该区域包含有其他的染色元素,将其像素值修改为背景均值,保证每个区域中仅有一个白细胞,进而得到规定尺寸的第一预训练图像,进而实现数据集的精确制作,保证后续训练得到的白细胞分类模型具有识别速度快、鲁棒性高、识别精度高的优点,进而能够快速且准确地实现对白细胞的分类和计数工作。To sum up, according to the above-mentioned generation method of the data set for the leukocyte classification model, firstly, multiple subfield images are regularly extracted from the eosin staining image, and at the same time, the first preset step size is smaller than the side length of the field frame used for extraction , to ensure that there are complete white blood cells in at least one sub-field image, and then quickly separate the sub-field images using the preset staining separation rules to obtain an eosin staining map containing white blood cells, and then pre-process each eosin staining map processing, and then separate the staining element and the background element, and then accurately identify the outline coordinates of the staining element according to the preset pixel range of the staining element, and then judge whether the staining element in the sub-field image is indeed a white blood cell, if it is judged that the staining element is For white blood cells, according to the contour coordinates of the dyed elements obtained before, the unprocessed sub-view image is pixel-divided and extracted. If the region contains other dyed elements, its pixel value is modified to the background mean value to ensure that each region There is only one white blood cell, and then the first pre-training image of the specified size is obtained, so as to realize the accurate production of the data set, and ensure that the white blood cell classification model obtained by subsequent training has the advantages of fast recognition speed, high robustness, and high recognition accuracy, and can further Fast and accurate classification and counting of white blood cells.
请参阅图5,所示为本发明第二实施例中的白细胞分类模型用数据集的生成方法的流程图,该方法包括步骤S101至步骤S107,其中:Please refer to FIG. 5 , which shows a flow chart of a method for generating a data set for a leukocyte classification model in the second embodiment of the present invention. The method includes steps S101 to S107, wherein:
步骤S101:获取包含白细胞的苏木精-伊红染色图,采用第一预设尺寸的视野框按照第一预设步长遍历所述苏木精-伊红染色图,以根据遍历结果从所述苏木精-伊红染色图中提取多份子视野图像,所述第一预设步长小于所述视野框的边长;Step S101: Obtain a hematoxylin-eosin staining map containing white blood cells, traverse the hematoxylin-eosin staining map according to a first preset step size using a field of view frame of a first preset size, and obtain from all Extracting multiple molecular field images from the hematoxylin-eosin staining image, the first preset step size is smaller than the side length of the field of view frame;
步骤S102:获取所述子视野图像中每个像素点的三通道像素值,以将每个像素点的三通道像素值转换为对应的光密度值,并根据像素点的光密度值构建一光密度矩阵;Step S102: Obtain the three-channel pixel value of each pixel in the sub-view image, convert the three-channel pixel value of each pixel into a corresponding optical density value, and construct a light source according to the optical density value of the pixel point density matrix;
具体的,根据以下公式将每个像素点的三通道像素值转换为对应的光密度值:Specifically, the three-channel pixel value of each pixel is converted into the corresponding optical density value according to the following formula:
其中,OD表示像素点的光密度值,value表示像素点的三通道像素值。Among them, OD represents the optical density value of the pixel point, and value represents the three-channel pixel value of the pixel point.
进一步的,即三通道像素值包括R、G、B像素值,并根据上述公式转换得到对应的光密度值,该光密度值构建的矩阵为二维矩阵,该二维矩阵中的每列的三个值分别是每个像素点的R、G、B三个OD值。Further, the three-channel pixel values include R, G, and B pixel values, and the corresponding optical density values are converted according to the above formula, and the matrix constructed by the optical density values is a two-dimensional matrix, and each column in the two-dimensional matrix The three values are the R, G, and B OD values of each pixel.
步骤S103:将所述光密度矩阵进行SVD矩阵分解,以根据矩阵分解结果拟合出一标准平面,并获取每个像素点光密度值在所述标准平面上的投影分量,并根据所述投影分量将所述子视野图像进行染色分离,得到所述伊红染色图;Step S103: Decompose the optical density matrix by SVD matrix to fit a standard plane according to the matrix decomposition result, and obtain the projection component of the optical density value of each pixel point on the standard plane, and according to the projection The component dyes and separates the subfield images to obtain the eosin staining image;
还需说明的是,在对该光密度矩阵进行分解时,进而得到矩阵中的前两列,即前两个奇异值对应的两个向量所知方向形成的平面,即为该标准平面,以使得经过OD变换的像素都被投影到这个标准平面上,产生的2个分量就是对应的苏木精染色图像与伊红染色图的OD值,而后再经过OD逆变换返回到RGB空间即得到分离出来的两种图像,即得到伊红染色图。It should also be noted that when the optical density matrix is decomposed, the first two columns in the matrix are obtained, that is, the plane formed by the known directions of the two vectors corresponding to the first two singular values is the standard plane, and All the pixels transformed by OD are projected onto this standard plane, and the two components generated are the OD values of the corresponding hematoxylin-stained image and eosin-stained image, and then returned to the RGB space through OD inverse transformation to be separated Two kinds of images come out, that is, the eosin staining map is obtained.
步骤S104:对所述伊红染色图进行灰度化处理,以降低所述伊红染色图中染色元素的灰度值,得到与每一伊红染色图一一对应的灰度图;Step S104: performing grayscale processing on the eosin-stained image to reduce the grayscale value of the dyed elements in the eosin-stained image to obtain a grayscale image corresponding to each eosin-stained image;
请参阅图6,所示为白细胞分割流程示意图,图6中的(a)为原始苏木精-伊红染色图(子视野图像),图6中的(b)为染色分离后伊红染色通道的RGB图像,即伊红染色图,由图6中的(b)可以看出,经过染色分离后,红细胞仍然有些许红色的残留阴影,为了过滤掉该残留阴影,同时最大限度地保留白细胞区域,需要将所述伊红染色图的亮度增强至第一预设倍数,进而得到图6中的(c),而后再对图像进行灰度化处理,得到图6中的(d),具体为:Please refer to Figure 6, which shows a schematic diagram of the leukocyte segmentation process, (a) in Figure 6 is the original hematoxylin-eosin staining image (subfield image), and (b) in Figure 6 is the eosin staining after staining separation The RGB image of the channel, that is, the eosin staining image, can be seen from (b) in Figure 6. After staining and separation, the red blood cells still have some residual red shadows. In order to filter out the residual shadows while retaining the white blood cells to the greatest extent area, it is necessary to enhance the brightness of the eosin staining image to the first preset multiple, and then obtain (c) in Figure 6, and then perform grayscale processing on the image to obtain (d) in Figure 6, specifically for:
获取亮度增强后的伊红染色图中的所有像素点的灰度值;Obtain the gray value of all pixels in the eosin staining map after brightness enhancement;
根据所有像素点的灰度值对亮度增强后的伊红染色图进行灰度变换;According to the gray value of all pixels, the brightness-enhanced eosin staining image is transformed into gray scale;
所述根据所有像素点的灰度值对亮度增强后的伊红染色图进行灰度变换的步骤包括:The step of performing grayscale transformation on the eosin stained image after brightness enhancement according to the grayscale values of all pixels includes:
根据以下公式对伊红染色图进行灰度变换:The grayscale transformation of the eosin-stained image was performed according to the following formula:
其中,i是指亮度增强后的伊红染色图中像素点的灰度值,G(x)是新的对应像素点的灰度值,[]表示取整数。Among them, i refers to the gray value of the pixel in the eosin staining image after brightness enhancement, G(x) is the gray value of the new corresponding pixel, and [] means to take an integer.
通过亮度增强以及上述特定公式对伊红染色图进行灰度化,能够使得背景与白细胞前景的差异增大,有利于后续对白细胞前景的精确提取。Graying the eosin staining image through brightness enhancement and the specific formula above can increase the difference between the background and the white blood cell foreground, which is conducive to the subsequent accurate extraction of the white blood cell foreground.
步骤S105:根据预设图像阈值对所述灰度图进行二值化分割,以将所述灰度图中的染色元素和背景元素进行分离,得到二值化图像。Step S105: performing binary segmentation on the grayscale image according to a preset image threshold, so as to separate the dyed elements and background elements in the grayscale image to obtain a binary image.
在得到的灰度图中,由于白细胞的灰度值、红细胞的灰度值、背景灰度值已经存在明显的差异,即白细胞的灰度值是远小于空白区域和红细胞这些背景的,基于此,设置固定阈值的分割方法以对灰度图进行二值化,得到图6中的(e)中的二值化图像,再对二值化图像进行形态学操作,进而得到图6中的(f),进而实现染色元素与背景元素的分离。In the obtained grayscale image, due to the obvious difference between the grayscale value of white blood cells, the grayscale value of red blood cells, and the background grayscale value, that is, the grayscale value of white blood cells is much smaller than the background of the blank area and red blood cells. Based on this , set a fixed threshold segmentation method to binarize the grayscale image to obtain the binarized image in (e) in Figure 6, and then perform morphological operations on the binarized image to obtain ( f), and then realize the separation of stained elements and background elements.
步骤S106:根据每一所述染色元素的轮廓坐标判断该染色元素是否为白细胞,若该染色元素为白细胞,则以该染色元素的轮廓中心点为分割中心从子视野图像中提取对应的固定大小的区域,得到多个第二预设尺寸的第一预训练图像;Step S106: Determine whether the dyed element is a white blood cell according to the contour coordinates of each dyed element, and if the dyed element is a white blood cell, extract the corresponding fixed size from the sub-view image with the center point of the contour of the dyed element as the segmentation center In the region, a plurality of first pre-training images of the second preset size are obtained;
进一步地,请参阅图7,所示为步骤S106的细化图,步骤S106包括步骤S1061至步骤S1064,其中:Further, please refer to FIG. 7 , which shows a detailed diagram of step S106. Step S106 includes steps S1061 to S1064, wherein:
步骤S1061:获取多张已知白细胞区域的标准图像,并根据标准图像中已知白细胞区域的轮廓坐标计算出每一白细胞的面积,并从所有白细胞的面积中筛选出最小面积值,以根据所述最小面积值和预设分割安全系数的比值计算得到标准面积值;Step S1061: Obtain a plurality of standard images of known white blood cell areas, and calculate the area of each white blood cell according to the outline coordinates of the known white blood cell areas in the standard image, and filter out the minimum area value from the areas of all white blood cells to obtain The standard area value is obtained by calculating the ratio of the minimum area value and the preset divisional safety factor;
步骤S1062:根据所述染色元素的轮廓坐标计算每一所述染色元素的面积,并判断所述染色元素的面积是否大于或等于所述标准面积值;Step S1062: Calculate the area of each dyed element according to the outline coordinates of the dyed element, and judge whether the area of the dyed element is greater than or equal to the standard area value;
步骤S1063:若所述染色元素的面积大于或等于所述标准面积值,则判断该染色元素为白细胞;Step S1063: If the area of the dyed element is greater than or equal to the standard area value, it is determined that the dyed element is a white blood cell;
需要说明的是,为了精确识别染色元素是否确为白细胞,首先会对少量已知确定白细胞区域的标准图像进行分析,以统计出一定数量的白细胞的面积,进而从这些白细胞的面积中筛选出最小面积,并设定一预设分割安全系数,以防止过滤掉白细胞。It should be noted that, in order to accurately identify whether the stained element is indeed a white blood cell, a small number of standard images of the known white blood cell area are first analyzed to count the area of a certain number of white blood cells, and then the smallest area of these white blood cells is screened out. area, and set a preset segmentation safety factor to prevent filtering out white blood cells.
示例而非限定,通过分析得到最小面积值为10000,则说明大于或等于10000的才可能是白细胞的细胞核,同时将预设分割安全系数设置为1.3,如果存在大于该比值的前景(白细胞),则将该子视野图像保留,否则将该子视野图像过滤掉。As an example and not a limitation, the minimum area value obtained through analysis is 10000, which means that the nucleus of a white blood cell may be greater than or equal to 10000, and the preset segmentation safety factor is set to 1.3. If there is a foreground (white blood cell) greater than this ratio, Then keep the sub-view image, otherwise filter the sub-view image.
步骤S1064:从所有的伊红染色图中筛选出染色元素为白细胞的目标图像,并根据遍历结果识别出任意相邻的两份目标图像,以根据相邻的两份目标图像中各自包含的白细胞的轮廓坐标判断相邻伊红染色图中的重叠区域是否存在重叠目标;Step S1064: Screen out the target images whose staining elements are leukocytes from all the eosin staining images, and identify any two adjacent target images according to the traversal results, so as to obtain the leukocytes contained in each of the adjacent two target images The contour coordinates of the adjacent eosin-stained image determine whether there is an overlapping target in the overlapping area;
还需重点指出的是,由于采用重叠切割的方法,该方法虽然会保证每个白细胞都至少有一个是完整的。但是会导致在重叠区域将同一个目标进行多次分割,造成数量虚假上升,为了解决这一问题,需要对相邻伊红染色图进行去重操作,具体为:It is also important to point out that due to the overlapping cutting method, although this method will ensure that at least one of each leukocyte is intact. However, it will cause the same target to be divided multiple times in the overlapping area, resulting in a false increase in the number. In order to solve this problem, it is necessary to perform deduplication operations on adjacent eosin stained maps, specifically:
根据第一目标图像中的第一白细胞的轮廓坐标计算得到所述第一白细胞所在区域的面积,根据第二目标图像中的第二白细胞的轮廓坐标计算得到所述第二白细胞所在区域的面积,所述第一目标图像和所述第二目标图像为相邻目标图像;The area of the area where the first white blood cell is located is calculated according to the outline coordinates of the first white blood cell in the first target image, and the area of the area where the second white blood cell is located is calculated according to the outline coordinates of the second white blood cell in the second target image, The first target image and the second target image are adjacent target images;
根据第一白细胞所在区域的面积和第二白细胞所在区域的面积计算得到两白细胞所在区域的交集和并集,并根据两白细胞所在区域的交集和并集计算得到第一交并比;The intersection and union of the areas where the two white blood cells are located are calculated according to the area of the area where the first white blood cells are located and the area where the second white blood cells are located, and the first intersection and union ratio is calculated according to the intersection and union of the areas where the two white blood cells are located;
判断所述第一交并比是否大于第一预设交并比阈值;judging whether the first intersection and union ratio is greater than a first preset intersection and union ratio threshold;
若所述第一交并比大于所述第一预设交并比阈值,则判定所述重叠区域中存在重复目标,并将第一目标图像和第二目标图像中面积最大的目标白细胞对应的图像保留,得到第二预训练图像。If the first intersection and union ratio is greater than the first preset intersection and union ratio threshold, it is determined that there are repeated targets in the overlapping area, and the target leukocyte corresponding to the largest area in the first target image and the second target image is The image is retained to obtain the second pre-training image.
示例性的,如果两个分割出来的子视野图像(伊红染色图)的IOU大于第一预设交并比阈值,那么可认定两个子视野图像的重叠区域存在同一个目标,此时将图片内部白细胞轮廓面积最大的保留,另一个删除,通过该方式来保证了每个白细胞的唯一性和完整性。Exemplarily, if the IOU of the two segmented sub-view images (eosin stained images) is greater than the first preset intersection-over-union ratio threshold, then it can be determined that the same target exists in the overlapping area of the two sub-view images, and the image will be The largest area of the inner leukocyte outline is retained and the other is deleted, in this way the uniqueness and integrity of each leukocyte is guaranteed.
具体的,第一预设交并比阈值若设置过低,则会增大计算复杂度,若设置过大则会影响重复目标消除的准确度,在本实施例中,第一预设交并比阈值设置为0.2,可以理解的,在实际分类计数过程中,第一预设交并比阈值可根据实际分类计数需求进行设置,以兼顾分类计数效率和准确度。Specifically, if the first preset intersection threshold is set too low, the computational complexity will increase, and if it is set too large, it will affect the accuracy of eliminating duplicate objects. In this embodiment, the first preset intersection The ratio threshold is set to 0.2. It can be understood that in the actual sorting and counting process, the first preset cross-merging ratio threshold can be set according to the actual sorting and counting requirements, so as to take into account the efficiency and accuracy of sorting and counting.
还要说明的是,在根据白细胞的染色元素的轮廓坐标将所述苏木精-伊红染色图或子视野图像进行分割的过程中,会结合后续的去重操作舍弃重复染色元素的轮廓坐标,即保证染色元素的轮廓坐标均与唯一的白细胞所对应,从而实现从原始图像(即图6中的(g))中对每个白细胞的精确提取,提取后的效果图请参阅图6中的(h)。It should also be noted that, in the process of segmenting the hematoxylin-eosin staining map or subfield image according to the contour coordinates of the staining elements of white blood cells, the contour coordinates of repeated staining elements will be discarded in combination with the subsequent deduplication operation , that is to ensure that the outline coordinates of the dyed elements correspond to the only white blood cells, so as to realize the accurate extraction of each white blood cell from the original image (ie (g) in Figure 6). Please refer to Figure 6 for the extracted rendering (h).
步骤S107:根据第一预训练图像包含的白细胞类型将所有的所述第一预训练图像进行标注分类,并根据标注分类结果将所有的第一预训练图像制成数据集,以根据所述数据集对预设初始白细胞分类模型进行训练,得到最终白细胞分类模型。Step S107: Label and classify all the first pre-training images according to the white blood cell types contained in the first pre-training images, and make all the first pre-training images into a data set according to the results of the label classification, so that according to the data Set to train the preset initial leukocyte classification model to obtain the final leukocyte classification model.
综上,根据上述的白细胞分类模型用数据集的生成方法,首先有规律地从伊红染色图中提取出多份子视野图像,同时第一预设步长小于用于提取的视野框的边长,以保证至少有一份子视野图像中存在完整的白细胞,而后利用预设染色分离规则快速将子视野图像进行快速分离,进而得到包含白细胞的伊红染色图,而后将每份伊红染色图进行预处理,进而分离出染色元素和背景元素,而后根据染色元素的预设像素范围精确识别出染色元素的轮廓坐标,进而判断出子视野图像中的染色元素是否确为白细胞,若判断到染色元素为白细胞,则按照之前获取到的染色元素的轮廓坐标对未处理前的子视野图像进行像素分割提取,如果该区域包含有其他的染色元素,将其像素值修改为背景均值,保证每个区域中仅有一个白细胞,进而得到规定尺寸的第一预训练图像,进而实现数据集的精确制作,保证后续训练得到的白细胞分类模型具有识别速度快、鲁棒性高、识别精度高的优点,进而能够快速且准确地实现对白细胞的分类和计数工作。To sum up, according to the above-mentioned generation method of the data set for the leukocyte classification model, firstly, multiple subfield images are regularly extracted from the eosin staining image, and at the same time, the first preset step size is smaller than the side length of the field frame used for extraction , to ensure that there are complete white blood cells in at least one sub-field image, and then quickly separate the sub-field images using the preset staining separation rules to obtain an eosin staining map containing white blood cells, and then pre-process each eosin staining map processing, and then separate the staining element and the background element, and then accurately identify the outline coordinates of the staining element according to the preset pixel range of the staining element, and then judge whether the staining element in the sub-field image is indeed a white blood cell, if it is judged that the staining element is For white blood cells, according to the contour coordinates of the dyed elements obtained before, the unprocessed sub-view image is pixel-divided and extracted. If the region contains other dyed elements, its pixel value is modified to the background mean value to ensure that each region There is only one white blood cell, and then the first pre-training image of the specified size is obtained, so as to realize the accurate production of the data set, and ensure that the white blood cell classification model obtained by subsequent training has the advantages of fast recognition speed, high robustness, and high recognition accuracy, and can further Fast and accurate classification and counting of white blood cells.
请参阅图8,所示为本发明第三实施例中的白细胞分类模型用数据集的生成系统的结构示意图,该系统包括:Please refer to FIG. 8 , which shows a schematic structural diagram of a system for generating a data set for a leukocyte classification model in the third embodiment of the present invention. The system includes:
子视野图像提取模块10,用于获取包含白细胞的苏木精-伊红染色图,采用第一预设尺寸的视野框按照第一预设步长遍历所述苏木精-伊红染色图,以根据遍历结果从所述苏木精-伊红染色图中提取多份子视野图像,所述第一预设步长小于所述视野框的边长;The subfield of view
染色图像分离模块20,用于基于预设染色分离规则对每份所述子视野图像进行染色分离,得到伊红染色图;Stained
进一步地,所述染色图像分离模块20还包括:Further, the stained
光密度矩阵构建单元,用于获取所述子视野图像中每个像素点的三通道像素值,以将每个像素点的三通道像素值转换为对应的光密度值,并根据像素点的光密度值构建一光密度矩阵;The optical density matrix construction unit is used to obtain the three-channel pixel value of each pixel in the sub-view image, so as to convert the three-channel pixel value of each pixel into a corresponding optical density value, and according to the optical density of the pixel Density values construct an optical density matrix;
染色分离执行单元,用于将所述光密度矩阵进行SVD矩阵分解,以根据矩阵分解结果拟合出一标准平面,并获取每个像素点光密度值在所述标准平面上的投影分量,并根据所述投影分量将所述子视野图像进行染色分离,得到所述伊红染色图。The dyeing separation execution unit is used to perform SVD matrix decomposition on the optical density matrix to fit a standard plane according to the matrix decomposition result, and obtain the projection component of the optical density value of each pixel point on the standard plane, and Staining and separating the sub-view images according to the projection components to obtain the eosin staining image.
图像预处理模块30,用于对每份所述伊红染色图进行预处理,以从所述伊红染色图中分离出染色元素和背景元素,并根据染色元素对应的预设像素范围获取预处理后的伊红染色图中满足所述预设像素范围的所有像素点坐标,以根据所述像素点坐标获取每一所述染色元素的轮廓坐标;An
进一步地,所述图像预处理模块30还包括:Further, the
灰度化处理单元,用于对所述伊红染色图进行灰度化处理,以降低所述伊红染色图中染色元素的灰度值,得到与每一伊红染色图一一对应的灰度图;a grayscale processing unit, configured to perform grayscale processing on the eosin staining image, so as to reduce the grayscale value of the dyeing elements in the eosin staining image, and obtain a gray scale corresponding to each eosin staining image degree map;
进一步地,所述灰度化处理单元还包括:Further, the grayscale processing unit also includes:
亮度增强子单元,用于将所述伊红染色图的亮度增强至第一预设倍数,并获取亮度增强后的伊红染色图中的所有像素点的灰度值;A brightness enhancement subunit, configured to enhance the brightness of the eosin-stained image to a first preset multiple, and obtain gray values of all pixels in the eosin-stained image after brightness enhancement;
灰度变换子单元,用于根据所有像素点的灰度值对亮度增强后的伊红染色图进行灰度变换;A grayscale transformation subunit, configured to perform grayscale transformation on the eosin dyed image after brightness enhancement according to the grayscale values of all pixels;
所述根据所有像素点的灰度值对亮度增强后的伊红染色图进行灰度变换的步骤包括:The step of performing grayscale transformation on the eosin stained image after brightness enhancement according to the grayscale values of all pixels includes:
根据以下公式对伊红染色图进行灰度变换:The grayscale transformation of the eosin-stained image was performed according to the following formula:
其中,i是指亮度增强后的伊红染色图中像素点的灰度值,G(x)是新的对应像素点的灰度值,[]表示取整数;Wherein, i refers to the gray value of the pixel in the eosin staining image after brightness enhancement, G(x) is the gray value of the new corresponding pixel, and [] represents an integer;
二值化处理单元,用于根据预设图像阈值对所述灰度图进行二值化分割,以将所述灰度图中的染色元素和背景元素进行分离,得到二值化图像;a binarization processing unit, configured to perform binarization segmentation on the grayscale image according to a preset image threshold, so as to separate the dyed elements and background elements in the grayscale image to obtain a binarized image;
染色元素分割模块40,用于根据每一所述染色元素的轮廓坐标判断该染色元素是否为白细胞,若该染色元素为白细胞,则以该染色元素的轮廓中心点为分割中心从子视野图像中提取对应的固定大小的区域,得到多个第二预设尺寸的第一预训练图像;The staining
进一步地,所述染色元素分割模块40还包括:Further, the dyeing
自适应阈值获取单元,用于获取多张已知白细胞区域的标准图像,并根据标准图像中已知白细胞区域的轮廓坐标计算出每一白细胞的面积,并从所有白细胞的面积中筛选出最小面积值,以根据所述最小面积值和预设分割安全系数的比值计算得到标准面积值;The adaptive threshold acquisition unit is used to obtain multiple standard images of known white blood cell areas, and calculate the area of each white blood cell according to the outline coordinates of the known white blood cell areas in the standard image, and select the smallest area from the areas of all white blood cells Value, to calculate the standard area value according to the ratio of the minimum area value and the preset divisional safety factor;
染色元素检测单元,用于根据所述染色元素的轮廓坐标计算每一所述染色元素的面积,并判断所述染色元素的面积是否大于或等于所述标准面积值;a dyeing element detection unit, configured to calculate the area of each of the dyed elements according to the outline coordinates of the dyed elements, and determine whether the area of the dyed element is greater than or equal to the standard area value;
染色元素判定单元,用于若所述染色元素的面积大于或等于所述标准面积值,则判断该染色元素为白细胞;a staining element determination unit, configured to determine that the staining element is a white blood cell if the area of the staining element is greater than or equal to the standard area value;
去重操作执行单元,用于从所有的伊红染色图中筛选出染色元素为白细胞的目标图像,并根据遍历结果识别出任意相邻的两份目标图像,以根据相邻的两份目标图像中各自包含的白细胞的轮廓坐标判断相邻伊红染色图中的重叠区域是否存在重叠目标;The deduplication operation execution unit is used to filter out the target images whose staining elements are leukocytes from all the eosin staining images, and identify any two adjacent target images according to the traversal results, so as to The contour coordinates of the leukocytes contained in each of them are used to determine whether there is an overlapping target in the overlapping area of the adjacent eosin staining map;
进一步地,所述去重操作执行单元还包括:Further, the deduplication operation execution unit further includes:
白细胞区域面积获取子单元,用于根据第一目标图像中的第一白细胞的轮廓坐标计算得到所述第一白细胞所在区域的面积,根据第二目标图像中的第二白细胞的轮廓坐标计算得到所述第二白细胞所在区域的面积,所述第一目标图像和所述第二目标图像为相邻目标图像;The white blood cell area acquisition subunit is configured to calculate the area of the area where the first white blood cell is located according to the outline coordinates of the first white blood cell in the first target image, and calculate the area of the area where the first white blood cell is located according to the outline coordinates of the second white blood cell in the second target image. The area of the area where the second white blood cells are located, the first target image and the second target image are adjacent target images;
第一交并比获取子单元,用于根据第一白细胞所在区域的面积和第二白细胞所在区域的面积计算得到两白细胞所在区域的交集和并集,并根据两白细胞所在区域的交集和并集计算得到第一交并比;The first intersection and union ratio acquisition subunit is used to calculate the intersection and union of the areas where the two white blood cells are located according to the area of the area where the first white blood cells are located and the area where the second white blood cells are located, and calculate the intersection and union of the areas where the two white blood cells are located. Calculate the first intersection and union ratio;
第一交并比检测子单元,用于判断所述第一交并比是否大于第一预设交并比阈值;A first intersection and combination ratio detection subunit, configured to determine whether the first intersection and combination ratio is greater than a first preset intersection and combination ratio threshold;
重复目标判定子单元,用于若所述第一交并比大于所述第一预设交并比阈值,则判定所述重叠区域中存在重复目标,并将第一目标图像和第二目标图像中面积最大的目标白细胞对应的图像保留,得到第二预训练图像。A repeated target judging subunit, configured to determine that there is a repeated target in the overlapping area if the first intersection and union ratio is greater than the first preset intersection and union ratio threshold, and compare the first target image and the second target image The image corresponding to the target white blood cell with the largest area is retained to obtain the second pre-training image.
数据集生成模块50,用于根据第一预训练图像包含的白细胞类型将所有的所述第一预训练图像进行标注分类,并根据标注分类结果将所有的第一预训练图像制成数据集,以根据所述数据集对预设初始白细胞分类模型进行训练,得到最终白细胞分类模型。The data set generating
综上,根据上述的白细胞分类模型用数据集的生成系统,首先有规律地从伊红染色图中提取出多份子视野图像,同时第一预设步长小于用于提取的视野框的边长,以保证至少有一份子视野图像中存在完整的白细胞,而后利用预设染色分离规则快速将子视野图像进行快速分离,进而得到包含白细胞的伊红染色图,而后将每份伊红染色图进行预处理,进而分离出染色元素和背景元素,而后根据染色元素的预设像素范围精确识别出染色元素的轮廓坐标,进而判断出子视野图像中的染色元素是否确为白细胞,若判断到染色元素为白细胞,则按照之前获取到的染色元素的轮廓坐标对未处理前的子视野图像进行像素分割提取,如果该区域包含有其他的染色元素,将其像素值修改为背景均值,保证每个区域中仅有一个白细胞,进而得到规定尺寸的第一预训练图像,进而实现数据集的精确制作,保证后续训练得到的白细胞分类模型具有识别速度快、鲁棒性高、识别精度高的优点,进而能够快速且准确地实现对白细胞的分类和计数工作。To sum up, according to the above-mentioned generation system of the data set for the leukocyte classification model, firstly, multiple subfield images are regularly extracted from the eosin staining image, and at the same time, the first preset step size is smaller than the side length of the field of view frame used for extraction , to ensure that there are complete white blood cells in at least one sub-field image, and then quickly separate the sub-field images using the preset staining separation rules to obtain an eosin staining map containing white blood cells, and then pre-process each eosin staining map processing, and then separate the staining element and the background element, and then accurately identify the outline coordinates of the staining element according to the preset pixel range of the staining element, and then judge whether the staining element in the sub-field image is indeed a white blood cell, if it is judged that the staining element is For white blood cells, according to the contour coordinates of the dyed elements obtained before, the unprocessed sub-view image is pixel-divided and extracted. If the region contains other dyed elements, its pixel value is modified to the background mean value to ensure that each region There is only one white blood cell, and then the first pre-training image of the specified size is obtained, so as to realize the accurate production of the data set, and ensure that the white blood cell classification model obtained by subsequent training has the advantages of fast recognition speed, high robustness, and high recognition accuracy, and can further Fast and accurate classification and counting of white blood cells.
本发明另一方面还提出一种可读存储介质,其上存储有一个或多个计算机程序,该程序被处理器执行时实现上述的白细胞分类模型用数据集的生成方法。Another aspect of the present invention also proposes a readable storage medium on which one or more computer programs are stored, and when the programs are executed by a processor, the above-mentioned method for generating a data set for a leukocyte classification model is realized.
本发明另一方面还提出一种计算机设备,包括存储器、处理器以及存储在存储器上并可在处理器上运行的计算机程序,所述处理器执行所述程序时实现如上述的白细胞分类模型用数据集的生成方法。Another aspect of the present invention also proposes a computer device, including a memory, a processor, and a computer program stored in the memory and operable on the processor. When the processor executes the program, the above-mentioned white blood cell classification model is implemented. How the dataset was generated.
本领域技术人员可以理解,在流程图中表示或在此以其他方式描述的逻辑和/或步骤,例如,可以被认为是用于实现逻辑功能的可执行指令的定序列表,可以具体实现在任何计算机可读介质中,以供指令执行系统、装置或设备(如基于计算机的系统、包括处理器的系统或其他可以从指令执行系统、装置或设备取指令并执行指令的系统)使用,或结合这些指令执行系统、装置或设备而使用。就本说明书而言,“计算机可读介质”可以是任何可以包含存储、通信、传播或传输程序以供指令执行系统、装置或设备或结合这些指令执行系统、装置或设备而使用的装置。Those skilled in the art will understand that the logic and/or steps shown in the flowchart or otherwise described herein, for example, can be considered as a sequenced list of executable instructions for implementing logical functions, which can be specifically implemented in on any computer-readable medium for use by an instruction execution system, apparatus, or device (such as a computer-based system, system including a processor, or other system that can fetch instructions from an instruction execution system, apparatus, or device and execute them), or Used in conjunction with these instruction execution systems, devices or equipment. For the purposes of this specification, a "computer-readable medium" may be any device that can store, communicate, propagate or transmit programs for use in or in conjunction with an instruction execution system, device or device.
计算机可读介质的更具体的示例(非穷尽性列表)包括以下:具有一个或多个布线的电连接部(电子装置),便携式计算机盘盒(磁装置),随机存取存储器(RAM),只读存储器(ROM),可擦除可编辑只读存储器(EPROM或闪速存储器),光纤装置,以及便携式光盘只读存储器(CDROM)。另外,计算机可读介质甚至可以是可在其上打印所述程序的纸或其他合适的介质,因为可以例如通过对纸或其他介质进行光学扫描,接着进行编辑、解译或必要时以其他合适方式进行处理来以电子方式获得所述程序,然后将其存储在计算机存储器中。More specific examples (non-exhaustive list) of computer-readable media include the following: electrical connection with one or more wires (electronic device), portable computer disk case (magnetic device), random access memory (RAM), Read Only Memory (ROM), Erasable and Editable Read Only Memory (EPROM or Flash Memory), Fiber Optic Devices, and Portable Compact Disc Read Only Memory (CDROM). In addition, the computer-readable medium may even be paper or other suitable medium on which the program can be printed, since the program can be read, for example, by optically scanning the paper or other medium, followed by editing, interpretation or other suitable processing if necessary. The program is processed electronically and stored in computer memory.
应当理解,本发明的各部分可以用硬件、软件、固件或它们的组合来实现。在上述实施方式中,多个步骤或方法可以用存储在存储器中且由合适的指令执行系统执行的软件或固件来实现。例如,如果用硬件来实现,和在另一实施方式中一样,可用本领域公知的下列技术中的任一项或它们的组合来实现:具有用于对数据信号实现逻辑功能的逻辑门电路的离散逻辑电路,具有合适的组合逻辑门电路的专用集成电路,可编程门阵列(PGA),现场可编程门阵列(FPGA)等。It should be understood that various parts of the present invention can be realized by hardware, software, firmware or their combination. In the embodiments described above, various steps or methods may be implemented by software or firmware stored in memory and executed by a suitable instruction execution system. For example, if implemented in hardware, as in another embodiment, it can be implemented by any one or combination of the following techniques known in the art: Discrete logic circuits, ASICs with suitable combinational logic gates, Programmable Gate Arrays (PGAs), Field Programmable Gate Arrays (FPGAs), etc.
在本说明书的描述中,参考术语“一个实施例”、“一些实施例”、 “示例”、“具体示例”、或“一些示例”等的描述意指结合该实施例或示例描述的具体特征、结构、材料或者特点包含于本发明的至少一个实施例或示例中。在本说明书中,对上述术语的示意性表述不一定指的是相同的实施例或示例。而且,描述的具体特征、结构、材料或者特点可以在任何的一个或多个实施例或示例中以合适的方式结合。In the description of this specification, descriptions referring to the terms "one embodiment", "some embodiments", "example", "specific examples", or "some examples" mean that specific features described in connection with the embodiment or example , structure, material or characteristic is included in at least one embodiment or example of the present invention. In this specification, schematic representations of the above terms do not necessarily refer to the same embodiment or example. Furthermore, the specific features, structures, materials or characteristics described may be combined in any suitable manner in any one or more embodiments or examples.
以上所述实施例仅表达了本发明的几种实施方式,其描述较为具体和详细,但并不能因此而理解为对本发明专利范围的限制。应当指出的是,对于本领域的普通技术人员来说,在不脱离本发明构思的前提下,还可以做出若干变形和改进,这些都属于本发明的保护范围。因此,本发明专利的保护范围应以所附权利要求为准。The above-mentioned embodiments only express several implementation modes of the present invention, and the description thereof is relatively specific and detailed, but should not be construed as limiting the patent scope of the present invention. It should be pointed out that those skilled in the art can make several modifications and improvements without departing from the concept of the present invention, and these all belong to the protection scope of the present invention. Therefore, the protection scope of the patent for the present invention should be based on the appended claims.
| Application Number | Priority Date | Filing Date | Title |
|---|---|---|---|
| CN202211617010.0ACN115620075B (en) | 2022-12-16 | 2022-12-16 | Method, system and device for generating data set for leukocyte classification model |
| Application Number | Priority Date | Filing Date | Title |
|---|---|---|---|
| CN202211617010.0ACN115620075B (en) | 2022-12-16 | 2022-12-16 | Method, system and device for generating data set for leukocyte classification model |
| Publication Number | Publication Date |
|---|---|
| CN115620075A CN115620075A (en) | 2023-01-17 |
| CN115620075Btrue CN115620075B (en) | 2023-03-14 |
| Application Number | Title | Priority Date | Filing Date |
|---|---|---|---|
| CN202211617010.0AActiveCN115620075B (en) | 2022-12-16 | 2022-12-16 | Method, system and device for generating data set for leukocyte classification model |
| Country | Link |
|---|---|
| CN (1) | CN115620075B (en) |
| Publication number | Priority date | Publication date | Assignee | Title |
|---|---|---|---|---|
| CN115830025B (en)* | 2023-02-16 | 2023-05-09 | 南昌大学 | Method, system, storage medium and computer equipment for classifying and counting white blood cells |
| CN116071746A (en)* | 2023-04-06 | 2023-05-05 | 北京寻因生物科技有限公司 | Cell image recognition analysis method |
| CN118967661B (en)* | 2024-10-10 | 2024-12-27 | 深圳市生强科技有限公司 | Cell growth monitoring method and device based on multiband light source camera |
| Publication number | Priority date | Publication date | Assignee | Title |
|---|---|---|---|---|
| CN104392460B (en)* | 2014-12-12 | 2015-11-04 | 山东大学 | A Segmentation Method of Adhesive Leukocytes Based on Nuclear Marker Watershed Transform |
| CN110909756A (en)* | 2018-09-18 | 2020-03-24 | 苏宁 | Convolutional neural network model training method and device for medical image recognition |
| CN110504032B (en)* | 2019-08-23 | 2022-09-09 | 元码基因科技(无锡)有限公司 | Method for predicting tumor mutation load based on image processing of hematoxylin-eosin staining tablet |
| US20210388424A1 (en)* | 2020-06-12 | 2021-12-16 | 10X Genomics, Inc. | Methods for analyzing target nucleic acids and related compositions |
| CN111798425B (en)* | 2020-06-30 | 2022-05-27 | 天津大学 | Intelligent detection method of mitotic figures in gastrointestinal stromal tumors based on deep learning |
| CN112801212B (en)* | 2021-03-02 | 2022-11-18 | 东南大学 | White blood cell classification counting method based on small sample semi-supervised learning |
| CN113221978A (en)* | 2021-04-27 | 2021-08-06 | 浙江师范大学 | Colorectal cancer digital pathological image discrimination method and system based on weak supervised learning |
| CN113570628B (en)* | 2021-07-30 | 2024-04-02 | 西安科技大学 | White blood cell segmentation method based on movable contour model |
| CN114004821A (en)* | 2021-11-05 | 2022-02-01 | 南京南数科技有限公司 | A Cascade-RCNN-Based Approach to Assisted Recognition of Enteric Ganglion Cells |
| Title |
|---|
| Sebastian Stenman.Antibody Supervised Training of a Deep Learning Based Algorithm for Leukocyte Segmentation in Papillary Thyroid Carcinoma.2020,全文.* |
| 金旭 ; 文可 ; 吕国锋 ; 石军 ; 迟孟贤 ; 武铮 ; 安虹 ; .深度学习在组织病理学中的应用综述.2020,(10),全文.* |
| Publication number | Publication date |
|---|---|
| CN115620075A (en) | 2023-01-17 |
| Publication | Publication Date | Title |
|---|---|---|
| CN115620075B (en) | Method, system and device for generating data set for leukocyte classification model | |
| CN115082683B (en) | Injection molding defect detection method based on image processing | |
| US10565479B1 (en) | Identifying and excluding blurred areas of images of stained tissue to improve cancer scoring | |
| US7558426B2 (en) | Device for outputting character recognition results, character recognition device, and program therefor | |
| JP6710135B2 (en) | Cell image automatic analysis method and system | |
| CN110334706B (en) | Image target identification method and device | |
| JP5174040B2 (en) | Computer-implemented method for distinguishing between image components and background and system for distinguishing between image components and background | |
| Ghosh et al. | Blood smear analyzer for white blood cell counting: a hybrid microscopic image analyzing technique | |
| US8335374B2 (en) | Image segmentation | |
| US5764792A (en) | Method and apparatus for processing images | |
| Zhou et al. | Leukocyte image segmentation based on adaptive histogram thresholding and contour detection | |
| CN112580748B (en) | Method for counting classified cells of stain image | |
| CN112949634B (en) | A method for detecting bird nests in railway contact network | |
| CN110570442A (en) | Contour detection method under complex background, terminal device and storage medium | |
| CN114581908A (en) | PD-L1 immunohistochemical scoring method, system, device and storage medium | |
| KR20230147130A (en) | Methods and apparatus for ranking images in a collection using image segmentation and image analysis | |
| CN113139936B (en) | Image segmentation processing method and device | |
| McHenry et al. | A geodesic active contour framework for finding glass | |
| CN116416621B (en) | Method and device for extracting text from an image with reflection | |
| CN114926386A (en) | Method and system for automatically segmenting leucocyte nucleoplasm based on deep learning | |
| CN113822869A (en) | Transparent soft packaging bag static detection method and system based on machine vision | |
| Anari et al. | Computer-aided detection of proliferative cells and mitosis index in immunohistichemically images of meningioma | |
| CN116823823A (en) | An artificial intelligence method for automatic analysis of cerebrospinal fluid cells | |
| Gim et al. | A novel framework for white blood cell segmentation based on stepwise rules and morphological features | |
| Vu et al. | Automatic extraction of text regions from document images by multilevel thresholding and k-means clustering |
| Date | Code | Title | Description |
|---|---|---|---|
| PB01 | Publication | ||
| PB01 | Publication | ||
| SE01 | Entry into force of request for substantive examination | ||
| SE01 | Entry into force of request for substantive examination | ||
| GR01 | Patent grant | ||
| GR01 | Patent grant | ||
| TR01 | Transfer of patent right | Effective date of registration:20250710 Address after:1002, Building A, Zhiyun Industrial Park, No. 13 Huaxing Road, Tongsheng Community, Dalang Street, Longhua District, Shenzhen City, Guangdong Province, 518000 Patentee after:Shenzhen Wanzhida Information Consulting Co.,Ltd. Country or region after:China Address before:999 No. 330000 Jiangxi province Nanchang Honggutan University Avenue Patentee before:Nanchang University Country or region before:China | |
| TR01 | Transfer of patent right |